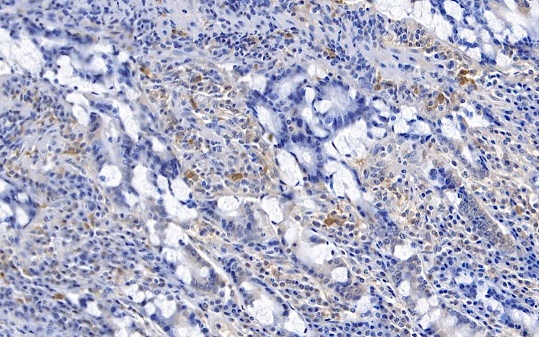
兔抗人IGG(FC)-HRP

兔抗人IGG(FC)-HRP
Rabbit anti-Human IgG(Fc)/HRP
询价
10μL
起订
湖北 更新日期:2026-04-05
产品详情:
- 中文名称:
- 兔抗人IGG(FC)-HRP
- 英文名称:
- Rabbit anti-Human IgG(Fc)/HRP
- 产品类别:
- 抗体
- 克隆性:
- 多克隆
- 货号:
- CSB-PA00540F0Rb
公司简介
武汉华美生物工程有限公司成立于2007年12月,是一家集科研、生产、销售为一体的生物高新技术企业,以科研试剂生产、诊断试剂原料供应、食品安全检测产品生产为核心,致力于为全球来自高等院校、政府研究机构、诊断试剂生产厂家以及生物制药公司的广大客户们提供高质量生物产品。
华美生物现拥有三大子品牌CUSABIO、科赛格(CUSAg)、维士康(WISHKON),分别经营抗体、蛋白、基因;科研试剂盒;诊断试剂原料产品和食品安全检测产品。
CUSABIO主要经营科研试剂产品,现拥有各物种基因产品500余万种;重组蛋白2,000,000多种;数十个种属的多克隆抗体50,000多种和高质量单克隆抗体数百种。 CUSABIO试剂盒,现已涵盖20个种属,数千种产品,涉及
| 成立日期 | (19年) |
| 注册资本 | 2000.000000万 |
| 员工人数 | 50-100人 |
| 年营业额 | ¥ 300万-500万 |
| 经营模式 | 试剂,定制,服务 |
| 主营行业 | 技术服务,生物技术服务 |
兔抗人IGG(FC)-HRP相关厂家报价 更多
-

- 兔抗人IGG(FC)-HRP
- 北京启维益成科技有限公司
- 2026-04-05
- 询价
-

- HRP标记山羊抗人IgG Fc端二抗
- 武汉艾美捷科技有限公司 VIP
- 2026-03-23
- 询价
-
- Alexa Fluor 488标记的兔抗小鼠IgG-Fc
- 北京索莱宝科技有限公司 VIP
- 2026-04-08
- ¥840.00
-

- 兔抗鼠IGG血清
- 北京博尔西科技有限公司
- 2026-04-05
- 询价
-

- 羊抗猪IGG-HRP
- 希施生物科技(上海)有限公司
- 2026-04-05
- 询价